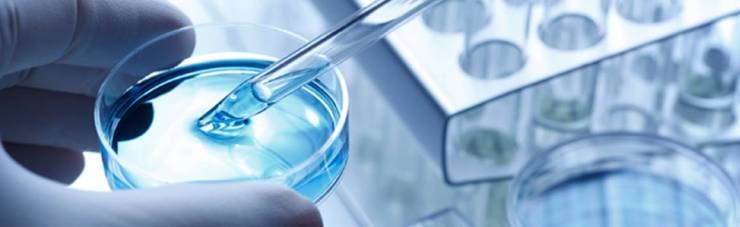
Cancer-Research

Liver Disease
- Living with PBC
- American Liver Foundation
- PBCers Organization
The PBCers is the largest PBC online support group worldwide consisting of patients, caregivers and family members, not medical professionals. - American Association for the Study of Liver Disease